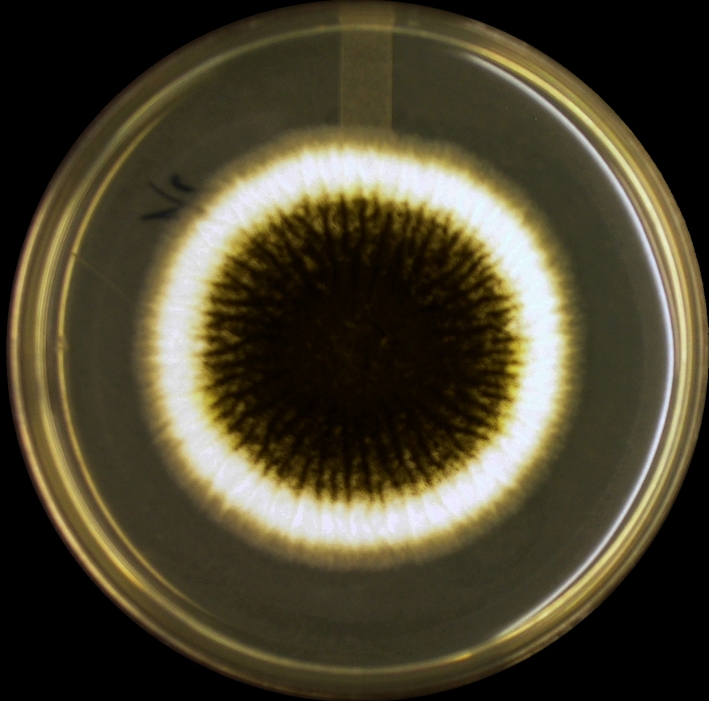

Аспергилл нигер: изображения и особенности вида

Раздел: Природная галерея